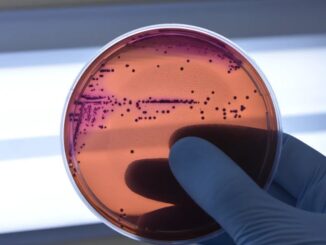

Antes e depois dos desenhos: Como a mudança nos hábitos de consumo afetou as crianças
Como a espera pelos desenhos animados ensinava paciência e mudava o comportamento infantil. Por Paloma de Sá | GNEWSUSA No passado, assistir a desenhos animados […]